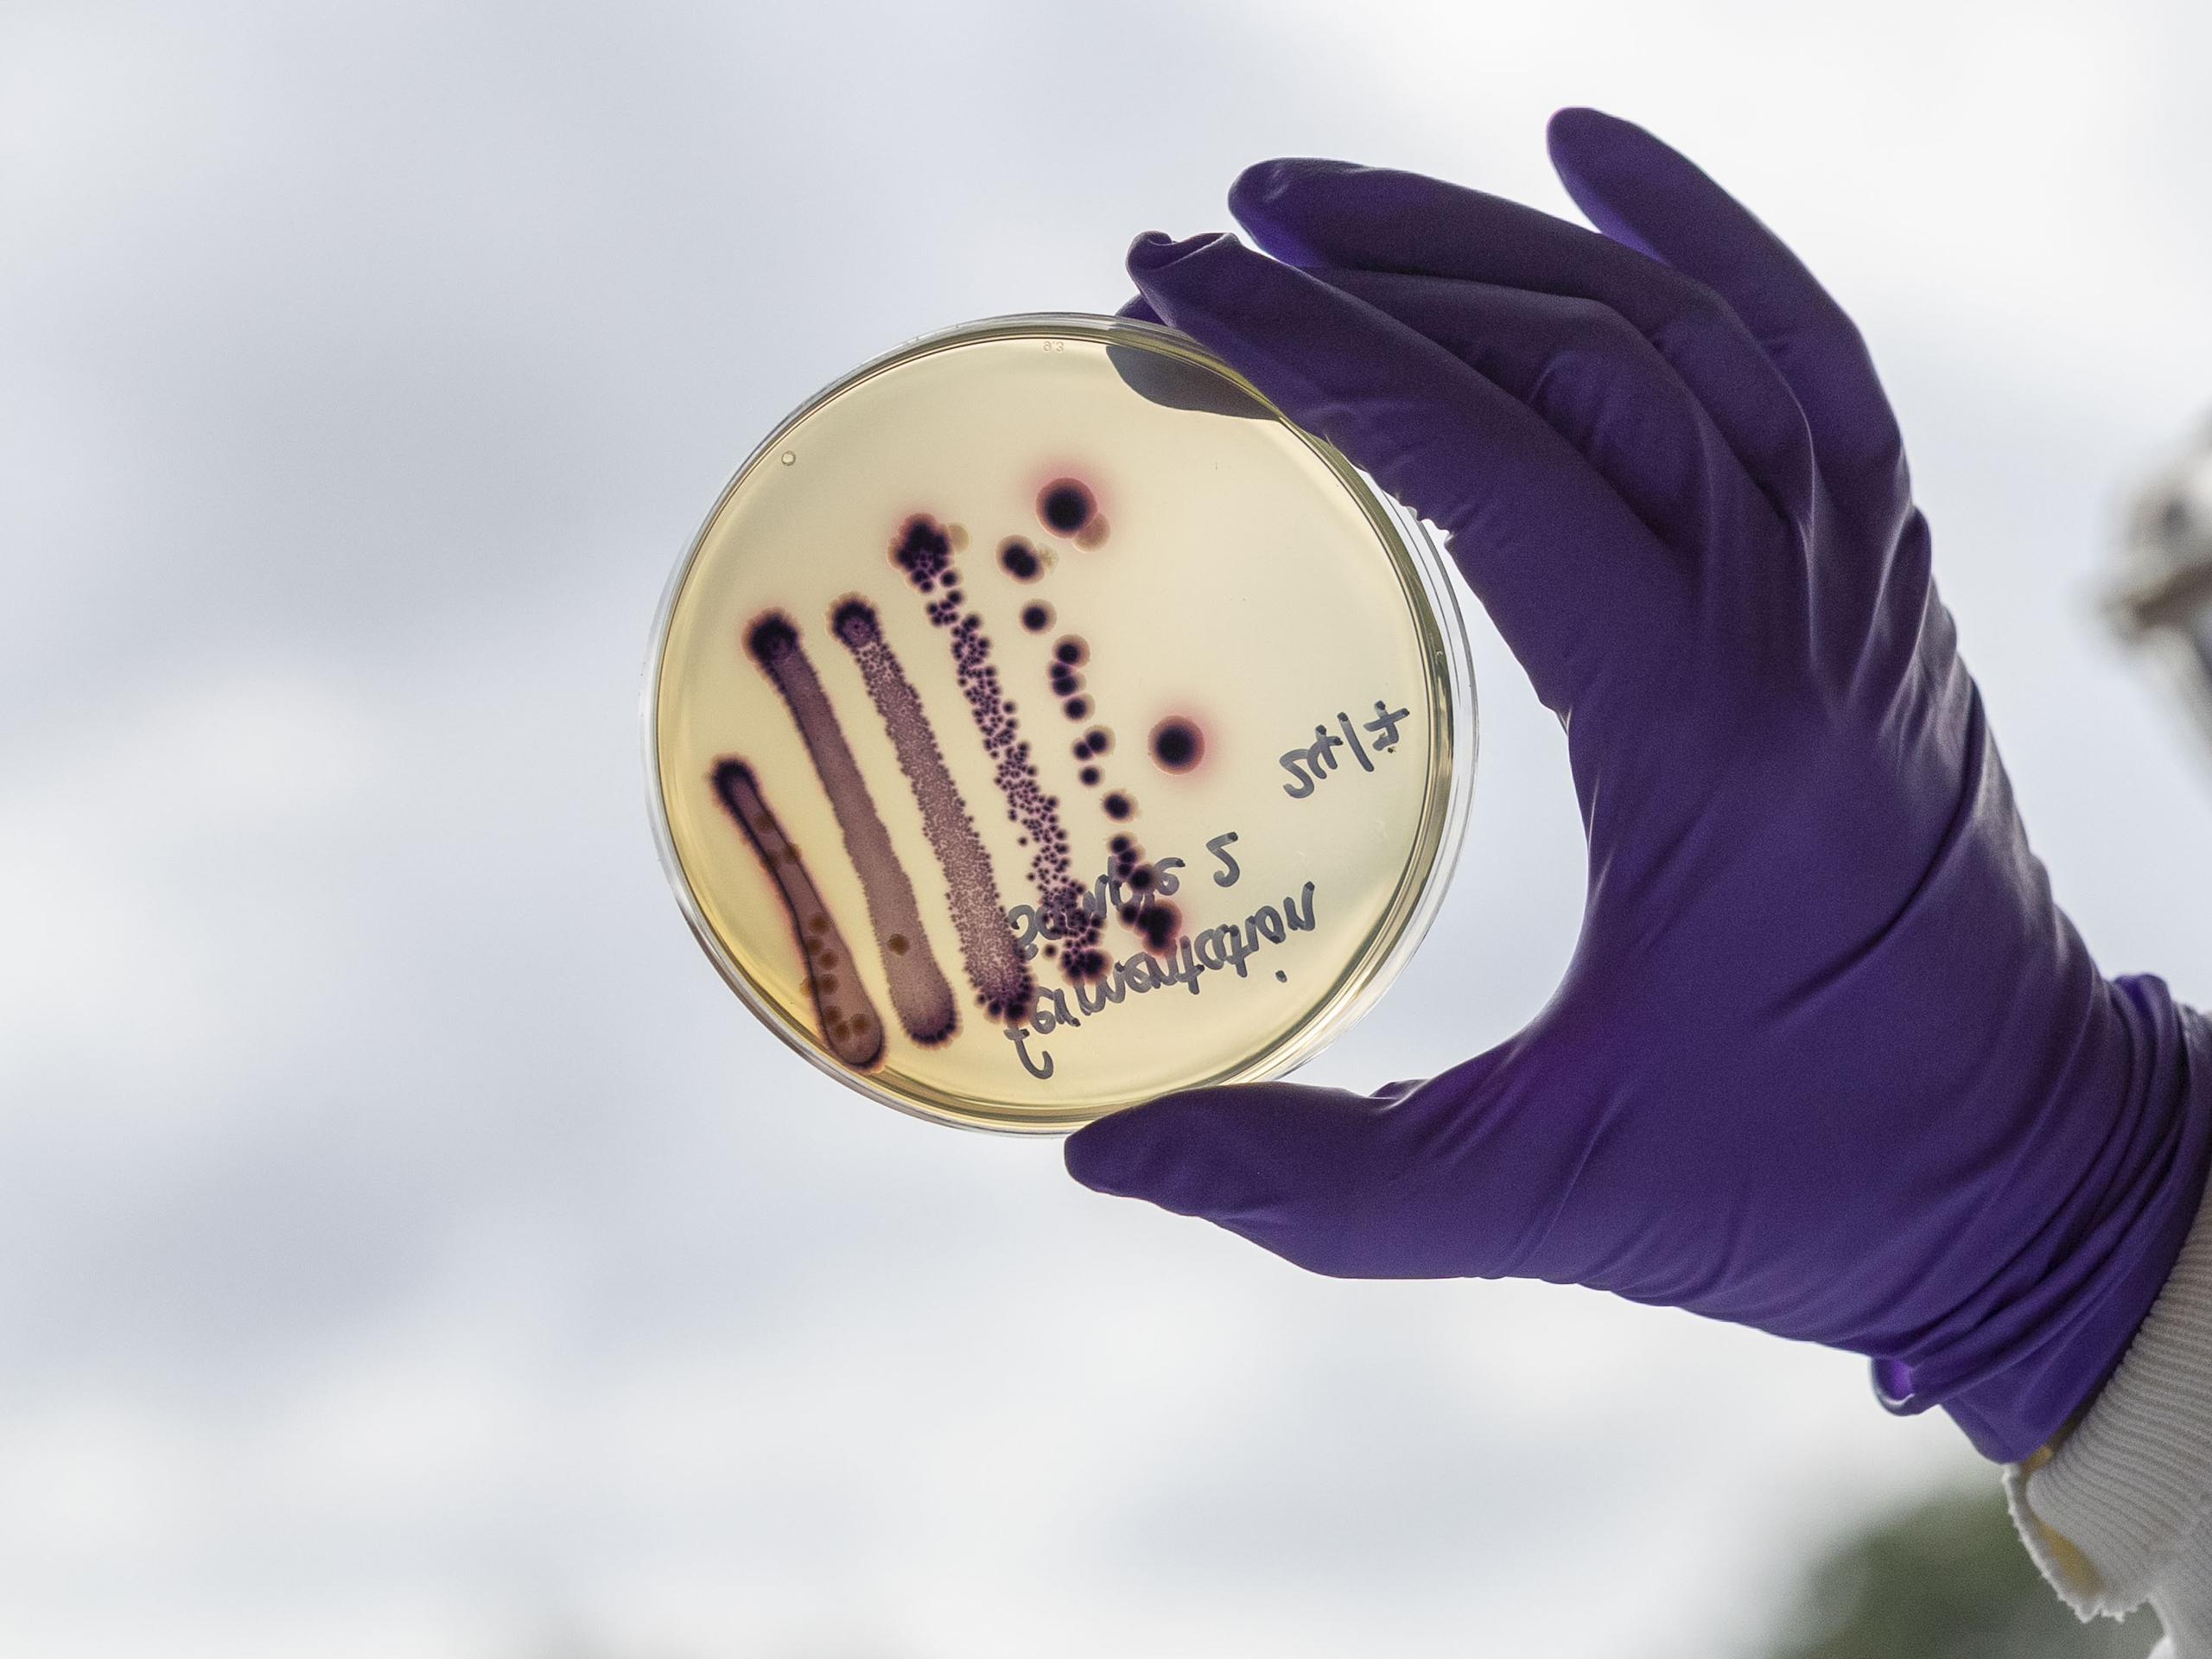
Accurate Diagnostics, Smarter Prescribing: The Twin Engines of Antimicrobial Stewardship

Diagnostics éclairés.
De meilleurs soins.
Des partenariats de confiance qui permettent une prise de décision diagnostique plus efficace et efficiente pour de meilleurs résultats en matière de santé animale.


Un service complet d’accompagnement pour une pratique efficace et efficiente.

Laboratoire de référence
Le plus grand réseau de laboratoires de référence vétérinaires et de services de consultation médicale spécialisés en Amérique du Nord.

Diagnostics internes
La gamme de diagnostics en clinique la plus complète du marché, comprenant la biochimie, l'hématologie, la coagulation, les gaz sanguins/électrolytes, la microscopie numérique, l'immuno-essai et les tests de flux latéral.

Son™ propulsé par Antech
Les équipements et solutions d’imagerie diagnostique les plus fiables, notamment la radiographie numérique, l’échographie, les lasers thérapeutiques et la tomodensitométrie.

Services d'imagerie
Des solutions d'imagerie diagnostique rapides et précises pour aider à fournir des soins de haute qualité, y compris des interprétations expertes de radiographies, de tomodensitométrie/IRM, d'ECG et de PennHip — et des solutions basées sur l'IA qui augmentent la confiance et l'efficacité.
Transform How You Detect Cancer
Free live webinar with oncology expert Dr. Sue Ettinger on November 19. Explore cutting-edge tools and strategies for early cancer screening and diagnosis—and earn one hour of RACE-approved CE credit.
Save Your Seat Now
truRapid™ FOUR
"With its speed, proven reliability, and streamlined workflow, trūRapid™ FOUR offers busy veterinary professionals a simple alternative to current testing protocols and, importantly, provides an affordable choice without compromising quality." — Dr. James Barr, DVM, DACVECC, Chief Medical Officer for Mars Petcare’s Science & Diagnostics
En savoir plus
-
Transform How You Detect Cancer
-
truRapid™ FOUR
Transform How You Detect Cancer
Free live webinar with oncology expert Dr. Sue Ettinger on November 19. Explore cutting-edge tools and strategies for early cancer screening and diagnosis—and earn one hour of RACE-approved CE credit.
Save Your Seat Now
truRapid™ FOUR
"With its speed, proven reliability, and streamlined workflow, trūRapid™ FOUR offers busy veterinary professionals a simple alternative to current testing protocols and, importantly, provides an affordable choice without compromising quality." — Dr. James Barr, DVM, DACVECC, Chief Medical Officer for Mars Petcare’s Science & Diagnostics
En savoir plus
Quoi de neuf chez Antech
-
Accurate Diagnostics, Smarter Prescribing: The Twin Engines of Antimicrobial Stewardship
-

Why Early Cancer Detection is Critical and Reliable: Affordable Diagnostic Solutions for Every Practice
-

One Health, one focus: how Antech is helping tackle the threat of vector-borne diseases
-

The ABCs of APPs: Assessing Inflammatory Disease with Acute Phase Proteins
-

Antech™ Expands trūRapid™ FOUR and trūRapid™ FIV/FeLV Rapid Tests to Canada After CFIA Approval